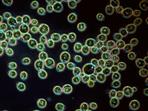

Home > Press > Ecotoxicity: All clear for silver nanoparticles? Silver gone astray
|
| Silver ions disrupt cellular metabolism in the green alga Chlamydomonas reinhardtii (photo), inhibiting functions such as photosynthesis. |
Abstract:
It has long been known that, in the form of free ions, silver particles can be highly toxic to aquatic organisms. Yet to this day, there is a lack of detailed knowledge about the doses required to trigger a response and how the organisms deal with this kind of stress. To learn more about the cellular processes that occur in the cells, scientists from the Aquatic Research Institute, Eawag, subjected algae to a range of silver concentrations.
Ecotoxicity: All clear for silver nanoparticles? Silver gone astray
Lausanne, Switzerland | Posted on February 25th, 2014In the past, silver mostly found its way into the environment in the vicinity of silver mines or via wastewater emanating from the photo industry. More recently, silver nanoparticles have become commonplace in many applications - as ingredients in cosmetics, food packaging, disinfectants, and functional clothing. Though a recent study conducted by the Swiss National Science Foundation revealed that the bulk of silver nanoparticles is retained in wastewater treatment plants, only little is known about the persistence and the impact of the residual nano-silver in the environment.
Infiltrating the energy metabolism undercover
Smitha Pillai from the Eawag Department of Environmental Toxicology and her colleagues from EPF Lausanne and ETH Z�rich studied the impact of various concentrations of waterborne silver ions on the cells of the green algae Chlamydomonas reinhardtii. Silver is chemically very similar to copper, an essential metal due to its importance in several enzymes. Because of that, silver can exploit the cells' copper transport mechanisms and sneak into them undercover. This explains why, already after a short time, concentrations of silver in the intracellular fluid can reach up to one thousand times those in the surrounding environment.
A prompt response
Because silver damages key enzymes involved in energy metabolism, even low concentrations can cut photosynthesis and growth rates by a half in just 15 minutes. Over the same time period, the researchers also detected changes in the activity of about 1000 other genes and proteins, which they interpreted as a response to the stressor - an attempt to repair silver-induced damage. At low concentrations, the cells' photosynthesis apparatus recovered within five hours, and recovery mechanisms were sufficient to deal with all but the highest concentrations tested.
A number of unanswered questions
At first glance, the results are reassuring because the silver concentrations that the algae are subject to in the environment are rarely as high as those applied in the lab, which allows them to recover quickly - at least externally. But the experiments also showed that even low silver concentrations have a significant effect on intracellular processes and that the algae divert their energy to repairing damage incurred. This can pose a problem when other stressors act in parallel, such as increased UV-radiation or other chemical compounds. Moreover, it remains unknown to this day whether the cells have an active mechanism to shuttle out the silver. Lacking such a mechanism, the silver could have adverse effects on higher organisms, given that algae are at the bottom of the food chain.
Text: Stefan Vogel/Andri Bryner
####
For more information, please click here
Contacts:
Dr. Smitha Pillai
+41 58 765 5255
Prof Dr. Kristin Schirmer
(Department Head of Environmental Toxicology)
+41 58 765 5266
Copyright © Ecole Polytechnique F�d�rale de Lausanne
If you have a comment, please Contact us.Issuers of news releases, not 7th Wave, Inc. or Nanotechnology Now, are solely responsible for the accuracy of the content.
| Related Links |
![]() Original article (Freely available online through the PNAS open access option):
Original article (Freely available online through the PNAS open access option):
| Related News Press |
News and information
![]() Simulating magnetization in a Heisenberg quantum spin chain April 5th, 2024
Simulating magnetization in a Heisenberg quantum spin chain April 5th, 2024
![]() NRL charters Navy�s quantum inertial navigation path to reduce drift April 5th, 2024
NRL charters Navy�s quantum inertial navigation path to reduce drift April 5th, 2024
![]() Discovery points path to flash-like memory for storing qubits: Rice find could hasten development of nonvolatile quantum memory April 5th, 2024
Discovery points path to flash-like memory for storing qubits: Rice find could hasten development of nonvolatile quantum memory April 5th, 2024
Discoveries
![]() Chemical reactions can scramble quantum information as well as black holes April 5th, 2024
Chemical reactions can scramble quantum information as well as black holes April 5th, 2024
![]() New micromaterial releases nanoparticles that selectively destroy cancer cells April 5th, 2024
New micromaterial releases nanoparticles that selectively destroy cancer cells April 5th, 2024
![]() Utilizing palladium for addressing contact issues of buried oxide thin film transistors April 5th, 2024
Utilizing palladium for addressing contact issues of buried oxide thin film transistors April 5th, 2024
Announcements
![]() NRL charters Navy�s quantum inertial navigation path to reduce drift April 5th, 2024
NRL charters Navy�s quantum inertial navigation path to reduce drift April 5th, 2024
![]() Discovery points path to flash-like memory for storing qubits: Rice find could hasten development of nonvolatile quantum memory April 5th, 2024
Discovery points path to flash-like memory for storing qubits: Rice find could hasten development of nonvolatile quantum memory April 5th, 2024
Environment
![]() Billions of nanoplastics released when microwaving baby food containers: Exposure to plastic particles kills up to 75% of cultured kidney cells July 21st, 2023
Billions of nanoplastics released when microwaving baby food containers: Exposure to plastic particles kills up to 75% of cultured kidney cells July 21st, 2023
Safety-Nanoparticles/Risk management
![]() Tests find no free-standing nanotubes released from tire tread wear September 8th, 2023
Tests find no free-standing nanotubes released from tire tread wear September 8th, 2023
![]() Billions of nanoplastics released when microwaving baby food containers: Exposure to plastic particles kills up to 75% of cultured kidney cells July 21st, 2023
Billions of nanoplastics released when microwaving baby food containers: Exposure to plastic particles kills up to 75% of cultured kidney cells July 21st, 2023
|
|
||
|
|
||
| The latest news from around the world, FREE | ||
|
|
||
|
|
||
| Premium Products | ||
|
|
||
|
Only the news you want to read!
Learn More |
||
|
|
||
|
Full-service, expert consulting
Learn More |
||
|
|
||








